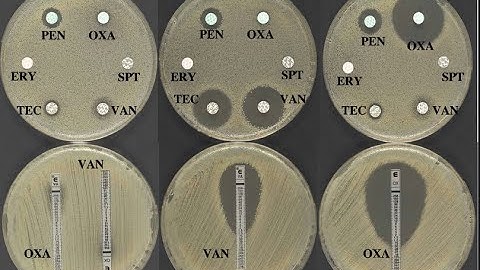
Disk diffusion assay: Kirby-Bauer Test

⬇ DOWNLOAD NOW
Kalau muncul iklan pop-up, tutup lalu klik tombol kembali
Download lagu How To Perform a Disk Diffusion Test (Modified Kirby-Bauer Test) secara gratis hanya untuk keperluan promosi. Dukung artis favorit kamu dengan membeli musik original di iTunes atau platform resmi lainnya.
 Testing an Antibiotic Using a Disk Diffusion Assay - Kirby Bauer Method
Testing an Antibiotic Using a Disk Diffusion Assay - Kirby Bauer Method
 Kirby Bauer Disk Diffusion Method
Kirby Bauer Disk Diffusion Method
 Disc Diffusion (Kirby-Bauer) Antimicrobial Susceptibility Testing
Disc Diffusion (Kirby-Bauer) Antimicrobial Susceptibility Testing
 How to do a Kirby-Bauer Disk Diffusion Antimicrobial Susceptibility Test
How to do a Kirby-Bauer Disk Diffusion Antimicrobial Susceptibility Test
 Kirby Bauer - Disc Diffusion Method for Antibiotic Susceptibility Testing
Kirby Bauer - Disc Diffusion Method for Antibiotic Susceptibility Testing
 Kirby Bauer Assay - Techniques Demonstration
Kirby Bauer Assay - Techniques Demonstration
Disk diffusion assay: Kirby-Bauer Test
Disk diffusion assay: Kirby-Bauer Test
 Disk Diffusion Test (Kirby-Bauer Test)
Disk Diffusion Test (Kirby-Bauer Test)